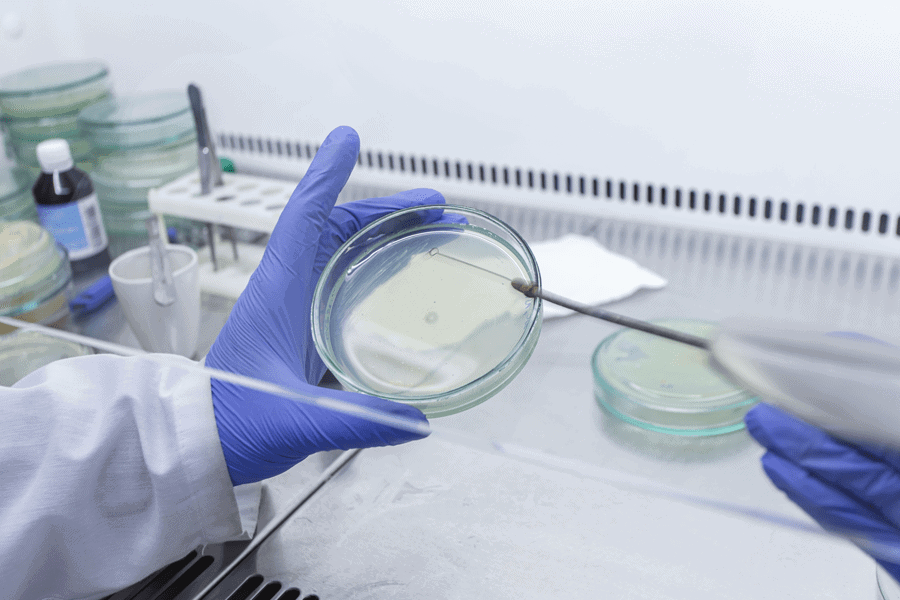
Sterile lab work with laminar flow hood gloves and face mask

How to Use a Laminar Flow Hood – The Complete Mycology Guide
Publié sous: Growing & Cultivation

The complete guide to using a laminar flow hood for sterile mushroom cultivation — what it is, when you need one, and how to get the most from it.
In this guide: Everything you need to know about the laminar flow hood — how it works, when to use it over a still air box, a step-by-step usage guide, and best practices to keep contamination out of your cultivation work.
New to sterile technique? Start with our guides on how to use a spore print and how to make agar plates. For the full sterilization picture, see how to sterilize cultivation materials.
If you have spent any time in the mushroom cultivation community, you have heard the term laminar flow hood mentioned alongside agar plates, grain spawn, and liquid culture syringes. It is held up as the gold standard for sterile work — the piece of equipment that separates serious cultivators from casual hobbyists. But what exactly is a laminar flow hood, when do you actually need one, and how do you use it correctly? This guide answers all of those questions in full.
What Is a Laminar Flow Hood?
A laminar flow hood — also called a clean bench or flow hood — is an enclosed workstation that creates a virtually contamination-free environment for sensitive tasks. It does this by pulling room air through a HEPA (High-Efficiency Particulate Air) filter, which captures 99.97% of airborne particles as small as 0.3 microns. The filtered air then flows across the work surface in a steady, uniform stream — that is the "laminar" part. Because the air moves in one direction with no turbulence, contaminants are continuously swept away from your open plates, jars, and cultures rather than allowed to settle on them.
The result is a workspace that mimics a professional laboratory cleanroom environment — one rated ISO 5 / Class 100 — but at a fraction of the cost and footprint. For mushroom cultivation, that means you can open petri dishes, pour agar, transfer mycelium, or inoculate grain jars without any meaningful risk of airborne contamination landing on your work.
Horizontal vs. Vertical Flow Hoods
There are two main configurations, and the difference matters for how you work:
| Horizontal flow hood | HEPA filter is mounted at the back; clean air blows horizontally toward you. This is the most common type for mushroom cultivation. The back-to-front airflow ensures your hands and tools stay downstream of critical surfaces, so you are not accidentally blowing contamination onto your open samples. |
| Vertical flow hood | HEPA filter is mounted on top; air blows downward onto the work surface. More common in pharmaceutical and clinical labs. Useful when working with taller equipment or when minimising the hood's footprint matters. |
For most home and small-scale commercial mushroom growers, a horizontal flow hood is the better choice. It gives you easy, unobstructed access to the work surface and keeps the airflow oriented so that any contamination from the room is pushed back away from your open cultures.
Tip: If you are choosing between horizontal and vertical, think about where your hands will be. In a horizontal hood, work close to the filter face — the cleanest zone is directly in front of the HEPA filter, and it becomes slightly less controlled the further forward you move. Keep equipment at least 6 inches back from the front opening.
Laminar Flow Hood vs. Still Air Box: Which Do You Need?
A still air box (SAB) works on a different principle: inside a sealed tub, air movement stops completely, so airborne particles settle downward rather than swirling over your work. It is an inexpensive, DIY-friendly solution that is perfectly adequate for many cultivation tasks — especially inoculating grain jars with spore swabs or working with spore prints.
A laminar flow hood actively replaces the air around your work with a constant stream of HEPA-filtered air. This is a fundamentally more reliable approach: instead of hoping the air has settled enough, you have a continuous, controlled environment. The tradeoff is cost and space — a quality flow hood costs several hundred euros or more, while a SAB can be built for almost nothing.
| Feature | Still Air Box | Laminar Flow Hood |
|---|---|---|
| Cost | Very low (DIY from a storage bin) | Higher (€300–€1000+ for a quality unit) |
| How it works | Stops air movement so particles settle | Replaces air with continuous HEPA-filtered flow |
| Workflow speed | Slower — must wait for air to settle after each movement | Faster — continuous clean air, work at your own pace |
| Best for | Beginners, simple inoculations, low-volume work | Agar work, culture transfers, high-volume or commercial grows |
| Agar plate work | Possible but challenging | Ideal — the gold standard for agar transfers |
| Room air quality sensitivity | High — room must be very clean and still | Low — the hood compensates for most room-level contamination |
Still Air Boxes (SAB's) come in different shapes and forms.The bottom line: Start with a still air box. When you are ready to work consistently with agar plates, prepare liquid cultures, or scale up your grows, a laminar flow hood is the upgrade that removes almost all the guesswork from sterile work.
When to Use a Laminar Flow Hood
A laminar flow hood is the right tool whenever you are doing work that is highly sensitive to airborne contamination — particularly any task where surfaces are exposed to open air for more than a few seconds. The most common uses in mushroom cultivation are:
Note: A laminar flow hood protects your work from airborne contaminants — it does not protect you from the work. If you are handling anything potentially harmful, use a biological safety cabinet (BSC) instead, which filters air both away from your samples and away from your face. For standard mushroom cultivation with Psilocybe cubensis spores or gourmet species, a standard horizontal flow hood is safe to use.
How to Use a Laminar Flow Hood: Step-by-Step
Owning a flow hood is only half the battle. Using it correctly — maintaining good technique inside the clean air zone — is what actually keeps contamination out. Follow these steps every time.
Choose a clean, low-traffic room
Your flow hood is producing clean air, but it cannot compensate for a room full of airborne spores, pet dander, or open windows. Close all windows and doors, turn off fans and air conditioning, and remove pets before you start. The cleaner the room, the less work your HEPA filter has to do and the longer it will last.
Turn on the flow hood and let it run for 15–30 minutes
Before touching anything sterile, give the hood time to purge any particles that may have settled on the filter surface or inside the housing since your last session. This warm-up period ensures the laminar air flow is fully established and the environment inside the hood is clean. Some cultivators run the hood for a full 30 minutes before any agar work; 15 minutes is generally sufficient for inoculations.
Wipe down all surfaces with 70% isopropyl alcohol
While the hood is warming up, wipe the work surface and the interior walls with 70% isopropyl alcohol. Do not spray directly onto the HEPA filter — this can damage the filter material over time. Wipe with a lint-free cloth or paper towel, and allow the alcohol to evaporate fully before you begin work. Do not use 99% IPA: the higher water content in 70% IPA slows evaporation and gives it better contact time with microbial cell walls, making it more effective as a disinfectant. You can also use alcohol swabs for quick spot-cleaning during the session. See our full guide on sterilization and disinfection methods for more detail on why concentration matters.
Prepare your tools and materials outside the hood
Gather everything you need before your session starts: your spore swabs, liquid culture syringes, jars or plates, scalpels, a butane torch lighter, alcohol swabs, and any other materials. Wipe the outside of every item with 70% IPA and let it dry. Place items on a rack or tray in front of the flow hood — not inside yet — so you can move them in as needed without repeatedly reaching in and out, which disrupts airflow.
Put on gloves and a face mask
Nitrile gloves eliminate fingerprint contamination and make it easy to spray-disinfect your hands between steps. A surgical face mask significantly reduces the number of particles you exhale over open containers. This is especially important when leaning over the work surface in a horizontal flow hood — your breath moves forward, into the clean air zone, rather than being blown back by the airflow. Pick up all your cultivation necessities before you start a session.
Work close to the HEPA filter face — the clean zone
In a horizontal flow hood, the cleanest air is directly at the filter face and becomes progressively less clean as you move toward the open front of the hood. Position your most sensitive materials — open petri dishes, agar plates, grain jars with lids removed — as close to the back of the work surface as practically possible. Keep equipment at least 6 inches from the front opening. Avoid placing large items between the filter and your open cultures, as they can create turbulence and shadow zones where the laminar flow breaks down.
Flame-sterilise all metal tools before each use
Even inside a flow hood, your scalpel blade, inoculation loop, or needle must be flame-sterilised before each transfer. Hold the metal tip in the flame of a butane torch lighter until it glows orange-red, then let it cool for five to ten seconds before touching any substrate or agar. A hot tool will kill mycelium on contact. Re-flame between every single transfer — never assume a tool is still sterile just because you set it down on a clean surface.
Work with slow, deliberate movements
Rapid hand movements inside the hood create turbulence that disrupts the laminar air flow. This can pull unfiltered room air into the clean zone — exactly what you are trying to prevent. Move slowly and methodically. Avoid reaching across open containers; instead, move the container to a position where you can approach it directly. Do not talk, sneeze, or cough toward your open work — turn your head to the side and away from the hood if needed.
Minimise the time open containers are exposed
Even in a flow hood, shorter exposure times mean lower contamination risk. Open jars, replace lids promptly. Lift the lid of a petri dish only as far as needed for the transfer, and close it immediately. Work one container at a time rather than having multiple open simultaneously unless the task specifically requires it.
Clean and shut down properly after each session
After finishing, wipe down the work surface again with 70% IPA. Remove all materials from inside the hood. Allow the hood to continue running for five minutes to clear any particles generated during your session, then switch it off. Never leave sterilised materials resting inside the hood when it is turned off — the lack of airflow means any contamination that lands on them during shutdown has no way to be cleared.
What You Need: Laminar Flow Hood Supplies Checklist
| Item | Purpose | Notes |
|---|---|---|
| Laminar flow hood (horizontal) | Creates the sterile clean air zone | Buy pre-built or build your own with a HEPA blower unit |
| 70% isopropyl alcohol + alcohol swabs | Disinfects surfaces, tools, and gloves | Do not spray directly on the HEPA filter. Single swabs are handy for spot-cleaning during a session |
| Sterile nitrile gloves | Keeps fingerprint contamination off sterile surfaces | Re-spray with IPA between each transfer |
| Surgical face mask | Reduces particles exhaled over open containers | A simple disposable mask is sufficient. Available with our cultivation necessities |
| Butane torch lighter | Flame-sterilises metal inoculation tools | A torch lighter gives a hotter, cleaner flame than a disposable |
| Scalpel or inoculation loop | For agar transfers and tissue cloning | Flame-sterilise before every single use. Browse cultivation tools |
| Spore swabs | Transfer spores directly onto agar plates inside the hood | One of the easiest ways to start a new culture — simply swipe across the agar surface |
| Liquid culture syringes | Fast-colonising mycelium ready for inoculation | Wipe the needle and vial with IPA before use. Ideal for grain spawn inoculations |
| Spore prints or spore syringes | Alternative genetic starting materials | Browse all available spores |
| Lint-free cloths or paper towels | Wiping down surfaces with IPA | Avoid anything that sheds fibres into the clean zone |
Laminar Flow Hood Maintenance
A flow hood is only as good as its HEPA filter. Neglecting maintenance leads to reduced airflow, dead spots in the clean air zone, and eventually contamination rates that defeat the purpose of having the hood at all.
Tip: Log your sessions. Noting the date, tasks performed, and any contamination outcomes helps you identify patterns — for example, a sudden spike in contam rates may point to a pre-filter that needs replacing rather than a technique problem.
Common Laminar Flow Hood Mistakes
Even with a laminar flow hood running, contamination can still happen if your technique is off. These are the mistakes cultivators make most often:
Ready to upgrade your sterile technique? Stock up on spore swabs and liquid culture syringes — the two most popular starting materials for flow hood work. Browse all cultivation necessities including sterile gloves and alcohol preps, or explore our full spore collection.

Avril 9, 2026